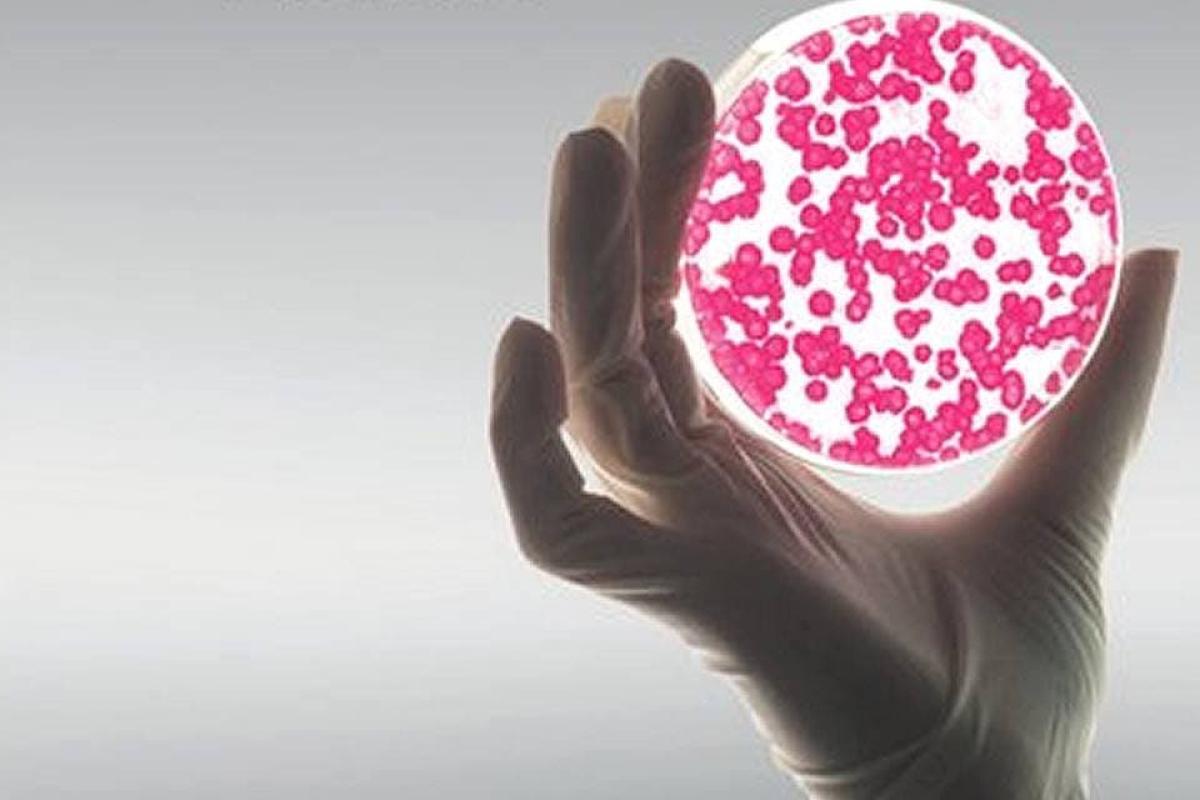

Embajada británica ofrece hasta $15 millones para chilenos con proyectos innovadores
Embajada británica ofrece hasta $15 millones para chilenos con proyectos innovadores
Embajada británica ofrece hasta $15 millones para chilenos con proyectos innovadores
T13 En Vivo
En el marco del Fondo Newton-Picarte, la embajada Británica en Chile y la fundación para la innovación agrícola (FIA), abren por segundo año la convocatoria a “proyectos de innovación joven 2016”.
El concurso se divide en dos etapas, y pretende capacitar a jóvenes con ideas en el sector forestal y agroalimentario. Tras ello, los mejores recibirán fondos semilla y podrán viajar a Reino Unido para recibir una mentoría.
El fondo tiene como objetivo la cooperación entre Chile y Reino Unido, en investigación científicas.
¿Quiénes pueden postular?
- Estudiantes y jóvenes profesionales entre los 18 y 30 años.
- El proyecto debe ser presentado solo por personas naturales.
- El participante debe tener un dominio básico del idioma inglés para participar en las actividades.
¿Qué proyectos pueden postular?
Las propuesta de proyectos de emprendimiento innovador, deben estar orientadas al menos a una de las siguientes tematicas:
- Adaptación al cambio climático
- Sustentabilidad ambiental
- Biotecnología
- Marketing agroalimentario
- Seguridad alimentaria
¿Qué beneficios reciben los seleccionados?
Primera etapa:
Se seleccionará a los 50 proyectos con más potencial, donde los jóvenes serán capacitados por expertos británicos en emprendimiento, planes de negocio y competitividad.
Segunda etapa:
Se elegirán a los 20 trabajos más destacados, podrán viajar a Inglaterra para capacitarse directamente con los modelos de negocios, innovación y tecnología del país europeo.
Además este llamado permite financiar hasta el 80% de sus proyectos con un tope máximo de $15 millones.
¿Cuánto dura el beneficio?
Tiene una duración máxima de 24 meses (2 años), e iniciará a partir del mes de noviembre del 2016.
¿Cómo puedo postular?
El postulante deberá entregar en un sobre los siguientes documentos:
- La propuesta original, en el formato “formulario de postulación” que puedes encontrar en FIA.
- Una copia digital de la propuesta en formato Word del “formulario de postulación”, que se puede entregar en CD o pendrive.
- Un video en inglés y español, de duración máxima de 3 minutos, donde se explique la propuesta.
¿Dónde postular?
En las oficinas de FIA ubicadas en Santiago, calle Loreley N°1582, en la Reina.
La propuesta también puede ser enviada por correo certificado a las oficinas de FIA.
¿Cuándo puedo postular?
La postulación inició el 11 de mayo y cierra el próximo 10 de junio del 2016.
Si necesitas más información revisa aquí las bases de postulación.









